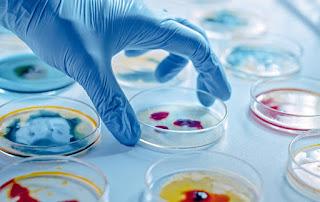
Descubren un tercer estado biológico que trasciende la vida y la muerte Descubren un tercer estado biológico que trasciende la vida y la muerte

Descubren un tercer estado biológico que trasciende la vida y la muerte
El mundo de la ciencia ha sido impactado por el reciente estudio que demostró un tercer estado de la biología que no es ni la vida ni la muerte. La investigación publicada por la Sociedad Estadounidense de Fisiología y tiene que ver con la presencia de células con la capacidad de seguir funcionando post-mórtem.
Sin dudas que en materia de ciencia y tecnología siempre se están llevando adelante distintos estudios con revelaciones de todo tipo. En el caso de la biología sintética, causó un gran sacudón tras el desarrollo de células que podrían ser utilizadas como biobots, incluso cuando el cuerpo de origen esté vivo o muerto.
Esto quiere decir que son células con la capacidad de seguir funcionando aún después de la muerte. El nombre que utilizaron es «tercer estado de la biología» y llevó a los científicos a hacerse muchas preguntas y comenzar un arduo estudio con respecto a este tema. Uno de los resultados de los expertos fue que podrían ser usadas como base para crear robots biológicos y que trabajen en áreas como la medicina.

El proceso de esta investigación todavía sigue en curso y el limbo entre la vida y la muerte de estas células podrían ser administradas en un cuerpo humano con el fin de que este repare células dañadas. Si bien este tema todavía sigue en constante investigación, los primeros resultados movilizaron a la ciencia y la biología porque de esta manera, se podrían reparar células neuronales dañadas, administrar medicinas de una forma más directa y hasta eliminar tumores. En última instancia, resaltaron que tienden a morir después de 60 días, por lo que su utilización debería ser en ese periodo de tiempo.
